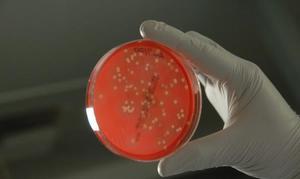
Las bacterias de las manos identifican a cada individuo

Las bacterias de las manos identifican a cada individuo
Las bacterias son una especie de huella dactilar capaz de desvelar la identidad de una persona gracias al rastro único que dejan, según un estudio llevado a cabo por biólogos y bioquímicos estadounidenses. El trabajo, publicado en la revista Proceedings of the National Academy of Sciences ... , abre la puerta al desarrollo de una nueva técnica de identificación forense.
"Cada uno de nosotros deja un rastro único de bacterias mientras realizamos nuestra vida diaria", señaló el autor principal del estudio, Noah Fierer, de la Universidad de Colorado-Boulde. Segun el biólogo, aunque la técnica aún está en su fase preliminar, "eventualmente puede convertirse en un valioso elemento en la caja de herramientas de los científicos forenses".
Aunque los científicos ya conocían la gran diversidad de microbios en las manos de los seres humanos -en la piel viven cientos de especies de ellas-, "la principal novedad fue demostrar que esas diferencias podían utilizarse para identificar los objetos tocados por las personas, gracias a los microbios que dejaban", ha explicado otro de los autores, Rob Knight. Según Fierer, la nueva técnica, basada en la secuenciación genética, tiene una precisión de entre el 70 y el 90 por ciento, un porcentaje que probablemente aumentará cuando se consiga perfeccionar el método.
En tres ordenadores
Fierer y su equipo recogieron muestras de ADN bacteriano de las teclas de tres ordenadores personales y las emparejaron con las bacterias de las manos de sus propietarios, para luego compararlas con muestras tomadas de otros teclados que jamás habían sido utilizados por esos sujetos. La similitud fue mucho mayor entre las bacterias de los individuos y las de sus propios ordenadores . Esta prueba también funcionó transcurridas 12 horas desde que los ordenadores fueron utilizados por última vez.
Y cuando los científicos tomaron muestras de la piel de dos individuos y congelaron una de ellas a menos 20 grados centígrados y dejaron la otra a temperatura ambiente durante dos semanas comprobaron que las colonias de bacterias no sufrieron cambios en ninguno de los casos, lo que demuestra el valor de los microbios para la medicina forense.
Esta técnica también puede ser valiosa para la medicina legal cuando es difícil obtener ADN humano al no existir rastros de sangre, tejido, semen o saliva en un objeto , según Fierer. "Debido a la abundancia de células bacterianas en la superficie de la piel podría ser más fácil recoger ADN bacteriano que ADN humano de las superficies tocadas", ha señalado.
Esta funcionalidad es sólo para suscriptores
Suscribete
Esta funcionalidad es sólo para registrados
Iniciar sesiónEsta funcionalidad es sólo para suscriptores
Suscribete